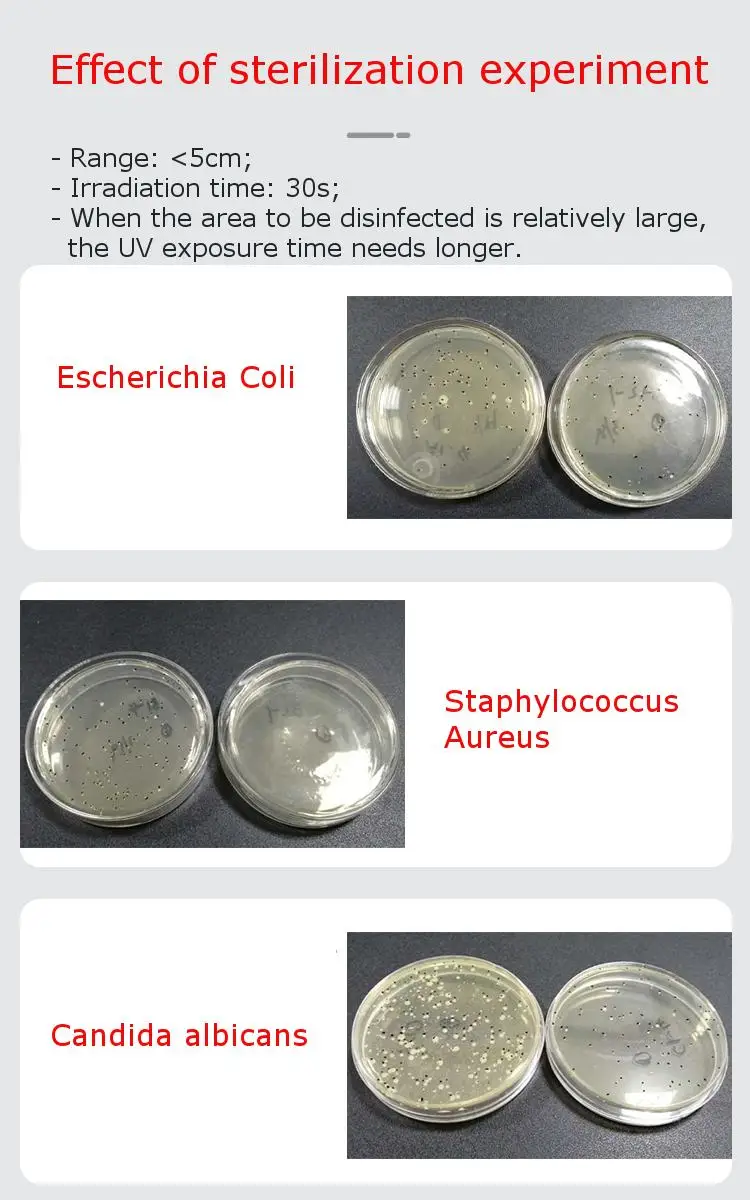

Astrolux MF01 Mini-UVC 7x UVC + лампа Уфа дезинфекция бактерицидный фонарик УФ
Сохраните в закладки:






История цены
*История изменения цены! Указанная стоимость возможно, уже изменилось. Проверить текущую цену - >
| Месяц | Минимальная цена | Макс. стоимость | Цена |
|---|---|---|---|
| Mar-24-2026 | 0.30 руб. | 0.24 руб. | 0 руб. |
| Feb-24-2026 | 0.18 руб. | 0.95 руб. | 0 руб. |
| Jan-24-2026 | 0.60 руб. | 0.62 руб. | 0 руб. |
| Dec-24-2025 | 0.80 руб. | 0.79 руб. | 0 руб. |
| Nov-24-2025 | 0.35 руб. | 0.54 руб. | 0 руб. |
| Oct-24-2025 | 0.57 руб. | 0.87 руб. | 0 руб. |
| Sep-24-2025 | 0.69 руб. | 0.30 руб. | 0 руб. |
| Aug-24-2025 | 0.5 руб. | 0.3 руб. | 0 руб. |
| Jul-24-2025 | 0.61 руб. | 0.61 руб. | 0 руб. |
Новые товары
Угловой миниатюрный светодиодный фонарь ильник NICRON перезаряжаемый с поворотом
Мультфункциональный LED-фонарик с вращающимся COB-рабочим светом, USB-зарядкой и мощным магнитом, подходит для кемпинга и езды на велосипеде.
Мощный фонарь 4LED-фонарик мини-портативная лампа с встроенной батареей 1200Ma 18650, заряжаемой по USB, COB LED Camping on.
Наборы 501B тактический фонарик XM-L T6 led 1/5 режимов 18650 лм батарея алюминиевый фонарь
Светодиодный фонарик 5 режимов P50 фонарь лампа AAA/18650/26650 регулируемое увеличение фокуса водонепроницаемый.
Фонарик XHP50 супермощный светодиодный тактический Водонепроницаемый фонарь с
Новинка Мини Портативный Карманный LED-фонарь С Зарядкой Факел Фонарик Водонепроницаемый Оптовая продажа с доставкой.
ASAFEE LED Подводный фонарь для дайвинга и фотографии XM-L2 с тактическим фонариком для скайбоббинга.
Характеристики
Astrolux MF01 Mini-UVC 7x UVC + лампа Уфа дезинфекция бактерицидный фонарик УФ
Описание товара

Технические характеристики
Название Astrolux MF01 Mini-UVC мощная лампа Бренд Астролюкс Модель MF01 Mini-UVC Режим стерилизации 7x UVC + UVA Длина волны УФ UVC275nm Питание от лампы 1,4 Вт Питание от стерилизации 21 МВт Функции Стерилизация, обнаружение Сопротивление падению 1,5 м Водонепроницаемый IPX7 Размер 111 мм * 44 мм * 34 ммДлина x Диаметр головки x Диаметр корпуса. Вес 170 г
Функции:
Обработка поверхности
Производство озона
Промышленная Подготовка воды
Дезинфекция
Стерилизовать
Красота
Промышленные поверхностные применения
Красота
Для принятия солнечных ванн
Промышленные поверхностные применения
UVC
Подходит для дома, офиса, деловых поездок, прогулок, путешествий, легко носить с собой и использовать.
Используйте ультрафиолетовый светильник, чтобы удалить бактерии, покрывающие изделия.
Поддерживать чистоту в комнате, шкафу и домашних предметах. Избегайте попадания бактерий.
Простое управление, просто нажмите кнопку переключения для стерилизации.
Вредные микробы и бактерии повсюду-на вашей кухне, в вашей ванной комнате, в вашей спальне, в вашей гостиной, в вашем рабочем месте и на большом количестве всего, что вы трогаете. Сейчас как никогда важно, чтобы эти пространства, где происходит жизнь, были здоровыми и безопасными для окружающей среды.
UVA
-Согласно янтару, аресту скорпионов и проверке билетов. Паспорт, кредитная карта, удостоверение личности.
-Детектор мочи домашних животных. Тест на мочу животных.
-Флуоресцентный порошок, обнаружение фосфорного агента.
-Руды, ювелирные изделия, обнаружение нефрита
-Отлично подходит для проверки банкнот, кредитных карт, флуоресцентных чернил (невидимых чернил), стеклянной посуды или даже места происшествия.
-Бумажные полотенца, маска для лица, косметика, детские игрушки, книги, одежда .......
Как это работает
Используйте его в пределах 5 см от объекта дезинфекции, и время облучения составляет 30 секунд.
(Известно, что UVC-LED 3 МВт с углом выхода 60 ° может убить 99.99% поверхности E. coli в течение 10 секунд на расстоянии 2 см.)
Режим и операции:
Управляйте Если Выкл сейчас Если на данный момент Нажмите на значок Включить до уровня 1 Level1 - Level2 - Level3. .. (режим цикла) Двойной щелчок Level3 (турбо-режим) Level3 (турбо-режим) Тройной щелчок Режим синхронизации выхода Режим синхронизации выхода Четыре нажатия Напряжение дисплея - Пять кликов Машинный замок Машинный замок Шесть кликов Тактический режим дезинфекции(Можно установить время дезинфекции) Тактический режим дезинфекции
(Можно установить время дезинфекции) Семь кликов Введите функцию синхронизации Введите функцию синхронизации (автоматически закройте через 10 минут)
Предупреждение:
Ультрафиолетовый UV-C светильник вреден для ваших глаз и кожи.
Не смотрите прямо на лампу и всегда используйте включенные УФ-очки при использовании этого инструмента.
Держите его подальше от детей, вам лучше нажать 5 раз, чтобы заблокировать устройство, когда вы его не используете.
Особенности:
1. 7x Мощные светодиоды
2. UVC275nm Короткая длина волны стерилизации и дезинфекции
3. Функция блокировки для предотвращения прикосновения детей
4. Использование кварцевая облатка стекла, коэффициент пропускания длины волны UVC лучше
5. Многофункциональная, как UVA лучи фонарик, флуоресцентная ручка обнаружения, стерилизация Ручка обнаружения, фальшивая Ручка обнаружения и т. Д.
Посылка включает в себя:
1 x Мощный мини-УФ-светильник Astrolux MF01
1 x очки
1 x ремешок
2 х запасных уплотнительных кольца
Подробнее о UVC
UVC
Длина волны от 200 до 275 нм, который также называется ультрафиолетовым светильник для стерилизации коротких волн. Он имеет самое слабое проникновение и не может проникать в большинство прозрачного стекла и пластика. Ультрафиолетовые бактерицидные лампы излучают ультрафиолетовые лучи с короткой длиной волны UVC.
Принцип ультрафиолетовой стерилизации
Ультрафиолетовая стерилизация заключается в разрушении и изменении структуры микроорганизмов (деоксирибонуклеиновой кислоты) с помощью ультрафиолетового излучения, чтобы бактерии могли немедленно или не размножаться и достичь цели стерилизации. Настоящий бактерицидный эффект-ультрафиолетовые лучи UVC, потому что ультрафиолетовые лучи C-band легко поглощаются DNA, RNA и белками организма.
Ультрафиолетовая стерилизация является чисто физическим методом дезинфекции. Он имеет преимущества простого и удобного, широкого спектра и высокой эффективности, без вторичного загрязнения, легкого управления и автоматизации. С введением различных новых дизайнов УФ-ламп, диапазон применения УФ-стерилизации постоянно расширяется.

Трекер стоимости
Отзывы покупателей
Новые отзывы о товарах
Шикарное платье, давно искала именно такое. Выполнено в винтажном стиле, и от него прямо веет духом тех лет. В нем... Читать отзыв полностью...
Отличный материал для рукоделия. Бусины яркие, без сколов, удобные в работе и недорогие. Из них получаются красивые браслеты, серьги, пояса... Читать отзыв полностью...
Нарядилась на свадьбу в это платье, и чувствовала себя без преувеличения, королевой. Вблизи оно просто супер - тончайшее кружево, белоснежная... Читать отзыв полностью...
Мне понравился дизайн, нечто похожее недавно видела в бутике. Но там босоножки стоили нереально, а на эти весьма посильная цена.... Читать отзыв полностью...
В детстве я обожал смотреть мультик по этой вселенной. Каждая битва прям наполняла адреналином и постоянно хотелось почувствовать себя на... Читать отзыв полностью...
Всем здравствуйте)купил и дочки такую курточку! Очень понравилась! Красивая, теплая, стильная, очень качественно выполнена! Удобные карманчики, очень вместительные!Легк о стирается,... Читать отзыв полностью...

















Очень эффектные босоножки, почти как у моей любимой певицы Леди Гаги. Взяла сразу два варианта, с сердечками и с цветочками.... Читать отзыв полностью...